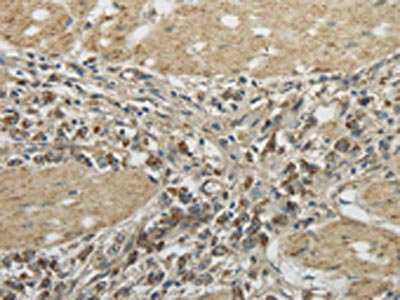

TRIB2 Antibody
-
中文名稱(chēng):TRIB2兔多克隆抗體
-
貨號(hào):CSB-PA255282
-
規(guī)格:¥1100
-
圖片:
-
其他:
產(chǎn)品詳情
-
Uniprot No.:
-
基因名:TRIB2
-
別名:C5FW antibody; FLJ57420 antibody; GS3955 antibody; Hypothetical protein TRB2 antibody; TRB-2 antibody; TRB2 antibody; TRIB 2 antibody; TRIB2 antibody; TRIB2_HUMAN antibody; Tribbles homolog 2 antibody
-
宿主:Rabbit
-
反應(yīng)種屬:Human,Mouse
-
免疫原:Full length fusion protein
-
免疫原種屬:Homo sapiens (Human)
-
標(biāo)記方式:Non-conjugated
-
抗體亞型:IgG
-
純化方式:Antigen affinity purification
-
濃度:It differs from different batches. Please contact us to confirm it.
-
保存緩沖液:-20°C, pH7.4 PBS, 0.05% NaN3, 40% Glycerol
-
產(chǎn)品提供形式:Liquid
-
應(yīng)用范圍:ELISA,IHC
-
推薦稀釋比:
Application Recommended Dilution ELISA 1:2000-1:10000 IHC 1:30-1:150 -
Protocols:
-
儲(chǔ)存條件:Upon receipt, store at -20°C or -80°C. Avoid repeated freeze.
-
貨期:Basically, we can dispatch the products out in 1-3 working days after receiving your orders. Delivery time maybe differs from different purchasing way or location, please kindly consult your local distributors for specific delivery time.
-
用途:For Research Use Only. Not for use in diagnostic or therapeutic procedures.
相關(guān)產(chǎn)品
靶點(diǎn)詳情
-
功能:Interacts with MAPK kinases and regulates activation of MAP kinases. Does not display kinase activity.
-
基因功能參考文獻(xiàn):
- Data indicate a regulatory mechanism underlying drug resistance and suggest that tribbles homologue 2 (TRIB2) functions as a regulatory component of the PI3K network, activating AKT in cancer cells. PMID: 28276427
- Due to the downregulation of MDR1 and MRP1, the intracellular accumulation of ADM was increased in the transfected cells compared with that in the parental K562/ADM cells..Our research revealed that protein expression of the ERK signaling pathway was inhibited by downregulating TRIB2, indicating that the ERK pathway was involved in cell drug resistance and proliferation. PMID: 29436678
- Trib2 is important for maintaining self-renewal in ES cells and for pluripotency induction during the reprogramming process. PMID: 29170476
- O-GlcNAcylation of TRIB2 might be critical for diabetes-associated liver cancer. PMID: 27515988
- Tumors from resistant patients expressed the lowest levels of TRIB2. Downregulation of TRIB2 contributes to platin-resistance. PMID: 28670762
- our data show that excess p30 cooperated with TRIB2 only in the presence of p42 to accelerate acute myeloid leukaemia (AML), and the direct interaction and degradation of C/EBPa p42 is required for TRIB2-mediated AML. PMID: 26996668
- miR-206 and miR-140, as tumor suppressors, induced lung adenocarcinoma cell death and inhibited cell proliferation by modifying oncogenic TRIB2 promoter activity through p-Smad3. PMID: 28005074
- Studied effect of TRIB2 SNP on the expression of genes involved in adaptive thermogenesis using messenger RNAs prepared from adipose tissues of Japanese adults. Of the five thermogenic genes, DIO2, CIDEA, PPARGC1A, and PRDM16 showed significantly higher transcript levels in SAT of individuals with the AA genotype relative to those with the AT + TT genotype. PMID: 28212671
- Data show that TRIB2-mediated degradation of CDC25C is associated with lysine-48-linked CDC25C polyubiquitination driven by the TRIB2 kinase-like domain. PMID: 27563873
- High TRIB2 reinforces the oncogenic transcriptional program controlled by the TAL1 complex in T-cell acute lymphoblastic leukemia. PMID: 26202930
- Studies suggest that tribbles homolog 2 (Drosophila) protein (TRIB2) as a meaningful biomarker to both diagnose and stage melanoma. PMID: 26517928
- Studies indicate that the molecular interactions that take place between tribbles homolog 2 (Drosophila) protein (TRIB2) and factors involved in the ubiquitin proteasome system (UPS) are varied and have differential downstream effects. PMID: 26517929
- The results suggest that TRIB2 is a meaningful biomarker reflecting diagnosis and progression of melanoma, as well as predicting clinical response to chemotherapy. PMID: 25586991
- Data suggest that TRB2 exhibits metal-independent autophosphorylation activity, low affinity ATP binding/hydrolysis, and a conserved catalytic lysine residue in the active site (rather than the asparagine in many metal-dependent kinases). PMID: 25583260
- TRIB2 negatively regulates Wnt activity through a reduction in protein stability of TCF4 and beta-Catenin PMID: 25311538
- we identify the contribution of dysregulated C/EBPalpha and E2F1 to elevated Trib2 expression and leukemic cell survival PMID: 24516045
- this study reveals that the stability and ubiquitination of TRIB2 can be also controlled by Ubiquitin E3 ligase SCFb-TRCP. PMID: 24211582
- impaired phosphorylation and ubiquitination by p70S6K and Smurf1 increase the protein stability of TRIB2 in liver cancer PMID: 24089522
- through regulating the expression of TRIB2 and its downstream factors, let-7c can effectively inhibit A549 cell proliferation in vitro and in vivo PMID: 23850892
- results illustrate that miR-511 and miR-1297 act as tumor suppressor genes, which could suppress A549 cell proliferation in vitro and in vivo by suppressing TRIB2 and further increasing C/EBPalpha expression PMID: 23071539
- Positive natural selection of TRIB2, a novel gene that influences visceral fat accumulation, in East Asia. PMID: 23108367
- Our findings here support the ability of high TRIB2 expression to reveal a T cell profile in both T cell acute lymphoblastic leukaemias and acute myeloid leukaemias. PMID: 22775572
- We have identified a SNP near the TRIB2 locus that is associated with pericardial fat but not with body mass index or visceral abdominal fat. PMID: 22589742
- Low Trib2 is associated with inflammatory bowel disease. PMID: 22271508
- TRIB2 as a potential driver of lung tumorigenesis through a mechanism that involves downregulation of C/EBPalpha PMID: 21399661
- our data demonstrate that Trib2 can bind both COP1 and C/EBP-alpha, leading to degradation of C/EBP-alpha. PMID: 20805362
- Downregulation potentiates IL-8 production by human monocytes via enhanced activation of the ERKs and JNK/MAPK pathways PMID: 18952906
- Trb-2 expression was reduced in acute myeloid leukaemia compared to healthy controls PMID: 20005259
- studies have found increased autoantibodies against Tribbles homolog 2 in narcolepsy PMID: 20614846
- A study reported an increased prevalence of autoantibodies against Tribbles homolog 2 (TRIB2) in patients with narcolepsy PMID: 20614847
- Overexpression of TRIB2 is associated with malignant melanoma. PMID: 20208562
- Elevated Tribbles homolog 2-specific antibody levels in narcolepsy patients. PMID: 20160349
- Anti-TRB2 antibody activities were detected in several autoimmune uveitis patients but not in control subjects, suggesting that TRB2 is a uveitis-associated candidate autoantigen. PMID: 15950723
- TRB2-Mcl-1 axis plays an important role in survival factor withdrawal-induced apoptosis of TF-1 erythroleukemia cells. PMID: 17545167
顯示更多
收起更多
-
亞細(xì)胞定位:Cytoplasm. Cytoplasm, cytoskeleton.
-
蛋白家族:Protein kinase superfamily, CAMK Ser/Thr protein kinase family, Tribbles subfamily
-
組織特異性:Highly expressed in peripheral blood leukocytes.
-
數(shù)據(jù)庫(kù)鏈接:
Most popular with customers
-
-
YWHAB Recombinant Monoclonal Antibody
Applications: ELISA, WB, IHC, IF, FC
Species Reactivity: Human, Mouse, Rat
-
Phospho-YAP1 (S127) Recombinant Monoclonal Antibody
Applications: ELISA, WB, IHC
Species Reactivity: Human
-
-
-
-
-